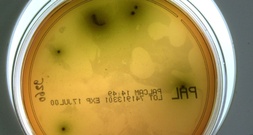
Rückruf von Lebensmitteln: Listerien sind häufigste Ursache

Als erste deutsche Politikerin seit dem Hamas-Überfall auf Israel im Jahr 2023 hat Bundestagspräsidentin Julia Klöckner (CDU) den Gazastreifen besucht. Die CDU-Politikerin hielt sich nach Angaben des Bundestags am Donnerstag etwa eine Stunde in dem von Israels Armee kontrollierten Teil des Gazastreifens auf, um sich dort einen eigenen Eindruck zu verschaffen. Die Bundestagspräsidentin befindet sich derzeit auf einem dreitägigen Antrittsbesuch in Israel.
Die Hamas hatte mit ihrem Überfall auf Israel am 7. Oktober 2023 den Krieg im Gazastreifen ausgelöst. Bei Massakern in Orten und bei einem Musikfestival im Süden Israels töteten die Islamisten 1221 Menschen, 251 Menschen verschleppten sie als Geiseln in den Gazastreifen.Â
Israel startete daraufhin eine Offensive im Gazastreifen. In den zwei sich anschließenden Kriegsjahren wurden nach nicht unabhängig überprüfbaren Angaben der Hamas-Behörden mehr als 71.600 Menschen getötet. Seit Oktober vergangenen Jahres ist eine brüchige Waffenruhe in Kraft.
Politik
Bundestagspräsidentin Klöckner zu Besuch im Gazastreifen
- AFP - 12. Februar 2026, 10:47 Uhr
Als erste deutsche Politikerin seit dem Hamas-Überfall auf Israel Bundestagspräsidentin Klöckner (CDU) den Gazastreifen besucht. Sie hielt sich eine Stunde dort auf.
Weitere Meldungen
Altbundeskanzlerin Angela Merkel (CDU) hat Spekulationen über eine Kandidatur für das Amt des Bundespräsidenten im kommenden Jahr zurückgewiesen. "Das ist abwegig", antwortete
MehrBei Protesten gegen eine Wahlkampfveranstaltung der AfD in Freiburg haben am Mittwochabend etwa 100 Vermummte versucht, gewaltsam eine Absperrung der Polizei zu durchbrechen.
MehrDie Bundesregierung hat den Generalinspekteur der Bundeswehr, Carsten Breuer, als Vorsitzenden des Nato-Militärausschusses nominiert. "Ich freue mich sehr, dass wir als
MehrTop Meldungen
Limburg (dts Nachrichtenagentur) - Bundeskanzler Friedrich Merz (CDU) und Frankreichs Präsident Emmanuel Macron haben am Donnerstag beim informellen EU-Gipfeltreffen in Belgien
MehrWegen eines Streiks der Piloten sind am Donnerstag reihenweise Flüge der Lufthansa ausgefallen. An den Flughäfen in Frankfurt, Berlin, Hamburg und Düsseldorf fielen ab dem
MehrWiesbaden (dts Nachrichtenagentur) - Im Jahr 2024 wurden in Deutschland 7,7 Milliarden Liter zuckerhaltige Cola, Limonaden und andere Erfrischungsgetränke hergestellt. Das
Mehr